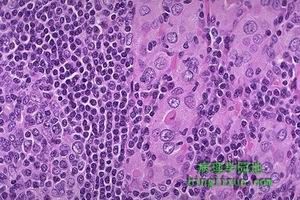
产后甲状腺炎

产后甲状腺炎
产后甲状腺炎(postpartumthyroiditis,PPT),是产后一年所发生的甲状腺功能异常综合征,可以为暂时性的也可以是永久性的。其病理基础是甲状腺自身免疫性炎症,是最常见而又最具有特征的产后自身免疫性甲状腺炎。妊娠5~20周流产后也可发生该病。产后甲状腺炎与产后甲状腺综合征是两种不同的概念。后者指原有或正在发生甲状腺疾病而在产后出现的甲状腺功能紊乱。 医学百科网 | YxBaike.Com
产后甲状腺炎曾有多种命名,这是与该病具有多种甲状腺疾病的特征有关。例如:产后无痛性甲状腺炎(postpartumpainlessthyroiditis,PPT)、寂静性甲状腺炎(silentthyroiditis,ST),即无疼痛的甲状腺炎、甲亢性甲状腺炎、无痛性亚急性甲状腺炎或不典型亚甲炎、淋巴细胞性甲状腺炎伴自发缓解的甲亢等。目前倾向于使用亚急性淋巴细胞性甲状腺炎(subacutelymphocyticthyroiditis)。亚急性淋巴细胞性甲状腺炎有两种发病形式:散发型和产后发病型。 医学百科网 | YxBaike.Com
医学百科网 | YxBaike.Com
 产后甲状腺炎
产后甲状腺炎患本症再次妊娠分娩后及2次妊娠之间,均可复发,复发率达25%~40%。本病偶可发生于Sheehan综合征产后。本病临床表现短暂,有时模糊不清而易被忽略。 医学百科网 | YxBaike.Com
甲状腺毒症:约50%发生,产后1~3个月出现,可持续1~2个月。其中只表现这一临床过程者为22.2%。食欲增加、体重下降、神经质等往往缺乏特异性,但心悸及乏力可能较为突出而成为就诊之主诉。如甲状腺毒症阶段超过2个月以上,往往症状较为明显,可伴有精神神经症状。51%甲状腺增大。表现为甲状腺肿出现或在原有基础上增大。多为轻度弥漫性肿大,质地均匀,偶尔仅有单个孤立结节,无触压疼痛。多无血管杂音。永久性甲状腺功能减退时可无甲状腺肿大。 医学百科网 | YxBaike.Com
短暂性甲状腺功能减退:25%~42.3%只有这一阶段表现。35.5%先后经历以上2个不同阶段。一般于产后3~6个月出现症状:水肿、体重增加、畏寒、食欲减退等。有时表现精神障碍,可误为抑郁症。本病循环甲状腺抗体阳性妇女抑郁症发生率增加达8.8%~30%。
医学百科网 | YxBaike.Com
有人停经或子宫出血,或出现伴有PRL增高的停经-溢乳综合征而误认为垂体病变。多数病人可于产后5~10个月内恢复正常。
医学百科网 | YxBaike.Com
永久性甲状腺功能减退:发生于10%~23%的病人。TPOAb阳性的本病妇女50%日后发生甲状腺功能减退,年发生率约为3%~5%。疾病早期发生一过性甲状腺功能减退者25%~30%发生永久性甲状腺功能减退症。而发生永久性甲状腺功能减退症者有92%在疾病早期出现一过性甲状腺功能减退。产后早期功能减退阶段TSH>20mU/L者,是日后长期甲状腺功能失调的预测指标。妊娠早期TPOAb滴度测定是预示本病发作后长期甲状腺功能减退的较好指标。多次妊娠与产后甲状腺炎后持久性甲状腺功能减退有相关关系。自然流产发生率与永久性甲状腺功能减退具有相关性;推测这些病人在妊娠期间具有轻度甲状腺功能不足而影响胎儿的生存能力。对于甲状腺功能减退症状明显,诊断后症状持续1年者应考虑永久性甲状腺功能减退症。产后第6个月,82%本病妇女发生激素异常,有些人无典型临床经过,就诊时已进入甲状腺功能减退阶段。也有病人产后功能亢进及功能减退期均不出现或出现不明显,体检时只有甲状腺肿大。本病一般于1年之内自行缓解。
医学百科网 | YxBaike.Com
医学百科网 | YxBaike.Com
1.自身免疫已证明本病与自身免疫关系密切。妊娠早期(前3个月)TPOAb阳性者,产后甲状腺炎发病率高达30%~50%。
2.遗传研究表明,本病具有HLA抗原多态性。 医学百科网 | YxBaike.Com
3.碘过量碘可诱发产后甲状腺炎。
4.既往有Graves病病史的妇女,产后无症状甲状腺炎尤为多见。
病毒分子
病毒分子1.自身免疫已证明本病与自身免疫关系密切。妊娠早期(前3个月)TPOAb阳性者,产后甲状腺炎发病率高达30%~50%。产后TPOAb水平高者往往提示其产后免疫反弹现象及免疫介导的甲状腺破坏程度严重。近些年也有人注意到妊娠早期自然或择期流产(包括异位妊娠)后1年内可发生甲状腺炎,类似于产后甲状腺炎,且在妊娠前抗体阳性者较抗体阴性者发生流产危险性高2倍。非足月妊娠的体内免疫学变化足以使患者发生产后甲状腺炎。 医学百科网 | YxBaike.Com
2.遗传研究表明,本病具有HLA抗原多态性。大量的临床及实验室研究也提示Hashimoto甲状腺炎与本病可能存在共同病因。HLA抗原与产后甲状腺炎发病相关性的解释可能为: 医学百科网 | YxBaike.Com
(1)该病位点与HLA位点连锁不平衡。也可能HLA在疾病过程中起直接作用。
(2)HLA的多态性可能是对抗原呈递细胞呈递特殊系列抗原肽能力的一种影响因素,因而可调节疾病的易感性。 医学百科网 | YxBaike.Com
3.碘过量碘可诱发产后甲状腺炎。甲状腺功能减退最容易发生在日摄碘量高于其日需要量的有本病病史的妇女。 医学百科网 | YxBaike.Com
本病产后发生的原因,一般认为,在妊娠期,母体出现免疫耐受(CD4阳性细胞比例下降,NK细胞活动受抑制等),允许接受胎儿移植。而产后母体免疫减弱的有关问题,包括胎盘因子及胎儿抑制性T细胞活性等问题尚未了解。产后这种抑制作用的减弱使免疫反应加剧,即产后出现的体液及细胞免疫的反弹介导了产后甲状腺炎的发生。病人在妊娠期多有甲状腺抗体的检出,表明先前存在有亚临床型自身免疫性甲状腺炎,产后恶化了这种异常。 医学百科网 | YxBaike.Com
甲状腺毒症阶段,推测低水平的甲状腺抗体破坏机制致甲状腺碘蛋白漏入循环而引起。所释放的激素可能是大分子复合物,这需要酶催化使之裂解为激素的活化形式进入循环,正常情况下这一过程由TPO所催化。血中甲状腺球蛋白在此阶段明显增高及碘排泄率增加支持这一解释。或可能解释为补体攻击甲状腺滤泡的结果。既往有Graves病病史的妇女,产后无症状甲状腺炎尤为多见。研究表明,产前有Graves病病史,产后甲状腺功能亢进再发时吸碘率检查结果或高或低,提示可能合并无症状甲状腺炎,但是,后者存在时间一般较短,易于忽略。同时,后者又可推迟或掩盖Graves病的发生发展。产后甲状腺炎的合并存在,或许是其Graves病加重或复发的主要原因。这些患者中,一部分因产后甲状腺炎使TSAb致高摄碘率降低,另一部分又可能只存在甲状腺轻度损害而对抗体的刺激有反应,造成不同的临床病象。有作者认为本病的存在及Graves病激活可能发生在伴有正常碘摄取的产后妇女。 医学百科网 | YxBaike.Com
甲状腺病理检查显示:局限性或广泛淋巴细胞及浆细胞浸润甲状腺组织,有时可见中央透明的滤泡存在。无生发中心及淋巴滤泡。有人认为本病是慢性淋巴细胞性甲状腺炎的变异。 医学百科网 | YxBaike.Com
医学百科网 | YxBaike.Com
诊断:
本病很易漏诊。对于产后甲状腺肿或加重,以往多归因于单纯性甲状腺肿。分娩后1年内出现疲乏、心动过速、神经质、甲状腺肿大或持续闭经者,应考虑本症。特别是妊娠期甲状腺肿及伴有高滴度甲状腺抗体的病人、有自身免疫甲状腺病家族史者,产后发生本病的危险性增加,需提高对本病的警惕性。产后出现甲状腺肿或甲状腺进行性增大,即使无功能改变也可能是产后甲状腺炎。前瞻性研究表明,甲状腺功能正常的产后甲状腺炎占4%。
实验室检查:
1.白细胞正常,红细胞沉降率(ESR)正常或轻度升高。
2.甲亢期间血清T3、T4增高,TSH减低。TSH抑制到可检出的最低限范围。TSH刺激也不能使其增加。 医学百科网 | YxBaike.Com
3.血清TG升高。血清TPO-Ab水平升高,但是其滴度相对于桥本甲状腺炎来说较低。约2/3病人甲状腺抗体阳性,TPO-Ab阳性率明显高于TGAb。极少数病人血清中存在TSAb,但出现的效价及时间与甲状腺病毒症发作及严重性无关。 医学百科网 | YxBaike.Com
4.甲状腺球蛋白(Tg)可增高,与甲状腺淋巴细胞浸润及腺体破坏相关;对诊断本病的敏感性为0.81,特异性0.98。
其他辅助检查: 医学百科网 | YxBaike.Com
1.甲状腺摄131Ⅰ率甲状腺毒症阶段明显降低。在功能低下阶段有所恢复。
2.过氯酸盐释放试验对产后甲状腺炎过后2~4年,甲状腺功能保持正常的妇女进行过氯酸盐释放实验证明,大部分病人过氯酸盐释放实验阳性,提示这些妇女存在持久性甲状腺碘有机化缺陷。这种缺陷与实验前甲状腺自身抗体阳性的滴度呈相关性。 医学百科网 | YxBaike.Com
3.甲状腺超声波检查可表现低回声。持续低回声可能预示甲状腺自身免疫破坏过程持续存在。
4.甲状腺穿刺活检由于产后甲状腺炎时甲状腺仅轻度增大,穿刺操作有困难,一般不作甲状腺穿刺活检。必要时做出的结果有利于诊断和鉴别诊断。 医学百科网 | YxBaike.Com
Graves病产后可加重或复发。突眼、甲状腺杂音或胫骨前黏液性水肿、甲状腺摄碘率增高而不同于本病。但可与本病同存,如合并存在,则碘摄取率不能作为鉴别诊断的依据,需测定TSAb,必要时甲状腺针吸细胞学检查加以鉴别。
医学百科网 | YxBaike.Com
1.β-肾上腺素能受体阻断药可改善甲状腺毒症症状。普萘洛尔30~60mg/d分次服用。 医学百科网 | YxBaike.Com
2.甲状腺激素可改善功能低下症状及缩小肿大的甲状腺。短暂性功能减退可应用数月至功能恢复正常并保持稳定后酌情停药。永久性甲状腺功能减退需终身替代治疗。
3.肾上腺皮质激素对预防再次妊娠复发可能有一定益处。有人主张分娩后即应用肾上腺皮质激素,泼尼松龙20mg/d,2个月后渐减量至停药。但目前尚无统一认识。 医学百科网 | YxBaike.Com
医学百科网 | YxBaike.Com
预后:大多数产后甲状腺炎病人甲状腺功能可在数月内恢复正常,对其自然病程的观察发现约有11%的病人可复发。TPO-Ab滴度持续升高者,有形成持续性甲减的倾向。TPO-Ab阳性者,持续性甲减发病率12%~30%。TPO-Ab阴性者,约有1.4%发展为持续性甲减。 医学百科网 | YxBaike.Com
预防:应避免给有本病病史妇女使用含碘药物,以避免诱发甲状腺功能减退症。妊娠妇女产前定期测定TPO-Ab对于预测该病的发生具有重要意义,特别对阳性抗体者应进行产后甲状腺功能的严密随访。由于在产后6个月82.2%的本病患者发生激素异常,故有研究者建议,对本病及高危人群应于6个月及以后进行随访。
产后甲状腺炎妇女多能重新恢复正常甲状腺功能。
产后甲状腺炎是一种破坏性甲状腺炎,其临床经过、病理生理及预后与无痛性甲状腺炎极为相似。通常发生于产后3~12个月内。产后妇女1.7%~16.7%发生本症,取决于研究的人群。较为确切的统计是3.7%~5.9%。在非选择人群的产后妇女发生率为4.9%。欧洲、亚洲及北美洲发病率为3.9%~8.2%,而泰国及英国不到2%。产后随访2~4年(威尔士)及5~16年(日本)证实发生甲状腺功能减退症者占23%,甚至达25%。也有报道,碘充足地区,在妊娠或产后期间甲状腺抗体阳性者,本病发生率为35%,明显高于总体妊娠妇女的4%~9%。
医学百科网 | YxBaike.Com
医学百科网 | YxBaike.Com
| 维生素D缺乏病 | 维生素C缺乏症 | 维生素A缺乏病 | 维生素E缺乏病 |
| 维生素B2缺乏症 | 心脏破裂 | 烟酸缺乏症 | 出血性疾病 |
附件列表
词条内容仅供参考,如果您需要解决具体问题,请遵医嘱或咨询医师。
本站词条内容如果涉嫌侵权,请与客服联系,我们将及时进行处理。如需转载,请注明来源于www.yxbaike.com
